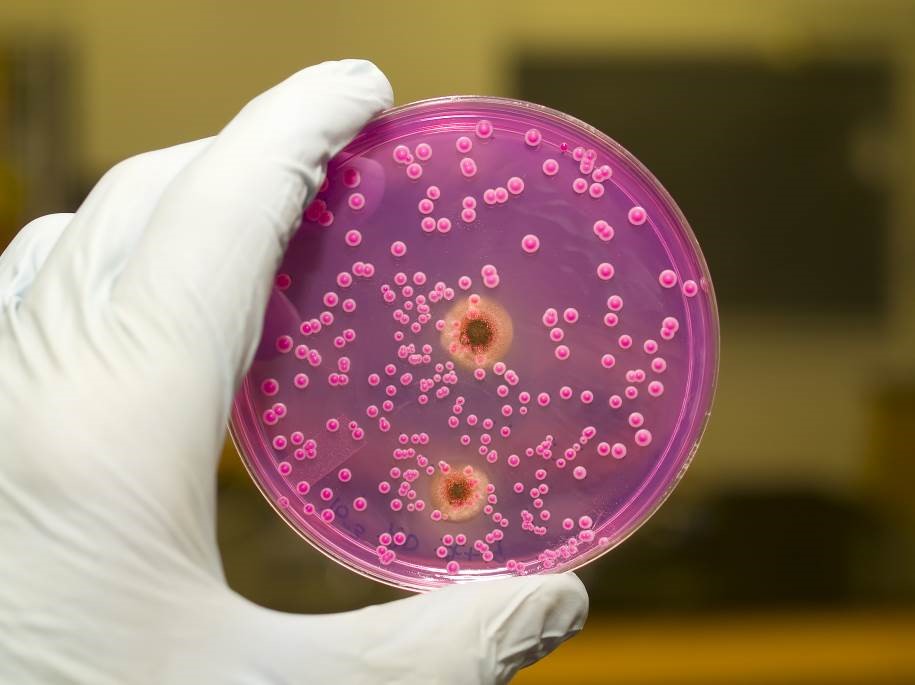
Otthoni tudnivalók az élelmiszer-biztonságról - Baktériumok és vírusok

Baktériumok és vírusok az élelmiszerekben
Szalmonellák
A szalmonellafertőzések gyakorisága az elmúlt 40 évben nőtt, főleg a csecsemők megbetegedései szaporodtak. A fertőzés forrásai legtöbb esetben a szárnyasok, de okozhatja háziállat is. A betegségek több mint 80%-a tojásfogyasztásra vezethető vissza. Egyre gyakrabban fordul elő, hogy nem csak a tojás héja, hanem belseje is fertőzött, amiben szerepet játszik a nagyüzemi állattartás. Ritkább esetben a fertőzés forrása lehet a beteg, illetve a tünetmentes baktériumhordozó ember, ha nem megfelelő higiéne mellett konyhai eszközökre, ételbe juttatja a kórokozót. A szalmonellák előfordulhatnak a fentieken kívül szennyvízben és felszíni vizekben is. Számukra optimális körülmények között hosszú ideig életképesek, pl. a tojáson vagy a vízben hónapokig túlélnek. A növekedésükhöz ideális a testhőmérséklet, de 7 és 47 °C között képesek szaporodni, de hő hatására gyorsan elpusztulnak. A betegség kialakulásához több milliós nagyságrendű baktériumot kell elfogyasztani, melyhez általában szükséges az ételkészítési folyamat szabálytalansága pl. sokáig tárolt hús, rövid ideig tartó hőkezelés, készétel lassú kihűtése vagy a nyers és sült húsok azonos vágódeszkán történő darabolása. Az érintkezés után 6–48 órán belül jelentkeznek a fő tünetek: rossz közérzet, hányás, hasmenés, láz. A betegség jó immunrendszerű személynél csupán néhány napig tart, de a gyógyulás után a fertőzésen átesettek akár hónapokig is üríthetik a szalmonellákat. Halálos kimenetelő fertőzős ritkán fordul elő, főleg csecsemők vagy legyengült, idős személyek körében. A fertőzést megelőzni csak a megfelelő állattartási és higiénés szabályok betartásával lehet, a legfontosabb a 60 °C feletti tárolás és a gyors 0–5 °C-ra történő lehűtés. Visszamelegítésnél el kell érni legalább a 70 °C-ot, 2 percen keresztül.
Campylobacter
Kutyák és macskák székletében és a szárnyasok húsában fordul elő leggyakrabban. A házi kedvenceknél hasmenést okoz. A kórokozó nagyon érzékeny a környezeti behatásokra, a hőkezelést, kiszáradást, pH-változást rosszul tűri. A 2–5 nap lappangási idő után a szalmonellához hasonló tüneteket okoz, és a terjedését is azonos szabálytalanságok okozzák, azzal a különbséggel, hogy a tojás ebben nem játszik szerepet. Megelőzhető megfelelő hőkezeléssel és az utószennyeződés kizárásával.
Yersinia
A kórokozó kimutatható a felszíni vizekben, szennyvízben, különféle állatokban és a ferőzött emberben is. Legfontosabb fertőző forrása a sertés, a legtöbb megbetegedés a háztáji vágások időszakában jelentkezik. A kórokozó érzékeny a környezeti hatásokra, azonban hűtőszekrényben túlél és szaporodni is képes. A fertőzés tünetei a bélhurut, a hasi nyirokcsomók gyulladása, de influenzaszerű tüneteket is produkál.
Kólibaktériumok
E baktériumok az ember és a legtöbb állatfaj bélrendszerében megtalálhatók, a környezetbe innen kerülnek. Egyes típusok hasmenéses betegségeket okoznak, de előfordulnak vesekárosodással és idegrendszeri tünetekkel járó fertőzések is.
Shigellák
A shigellák okozta fertőzés a vérhas, mely csak az ember megbetegedését okozza, a fertőző forrás is csak az ember lehet. Leggyakrabban tejjel és tejtermékekkel terjed, amik érintkeztek valamilyen módon az emberi széklettel. A tünetek 12–48 órás lappangási idő után jelentkeznek: híg, nyákos, véres széklet, hasi görcsökkel és lázzal. Megelőzésének legfontosabb módja a személyi higiéne betartása és a gyakori kézfertőtlenítés.
Clostridiumok
A „kolbászmérgezés” okozói fellelhetők a talajban, porban, felszíni vizekben és az állatok bélcsatornájában egyaránt. A baktérium ellenáll a környezeti hatásoknak, de csak levegőtől elzárt helyen tud szaporodni és mérget termelni (pl. töltelékes áruk belsejében). Legtöbbször a házilag előállított húskészítmények okozzák a fertőzést. A baktérium által termelt méreganyag elfogyasztása mikrogrammos mennyiségben is halálos kimenetelű. A toxin hőérzékeny, ezáltal könnyen hatástalanítható. A tünetek 12–48 óra után jelentkeznek: kezdetben hányás, hasmenés, majd idegrendszeri tünetek következnek, tág pupilla, látásromlás, nyelési nehezítettség. Ellátás hiányában a halált légzésbénulás okozza. Megelőzni a megfelelő húsfeldolgozással és hőkezeléssel lehet.
Vírusok
A vírusok önmagukban nem mutatnak életjelenségeket, nincs anyagcseréjük, önálló mozgásra képtelenek. Élő anyagként csak gazdaszervezetben, annak folyamatait felhasználva működnek. Az élelmiszerek a vírusok terjesztésében csak passzív, közvetítő szerepet játszanak, hiszen a vírusok ebben a közegben sem képesek szaporodni, vagy méreganyagot termelni. Mégis több olyan járványos betegség létezik, amihez köthető az élelmiszerben jelen lévő vírus.
A világon az egyik leggyakoribb ivóvíz és élelmiszerek által terjesztett vírus a hepatitis A vírusa, ami májgyulladást okoz.
A vírusok élelmiszerbe kerüléséhez mindig szükség van egy fertőző forrásra, azaz egy beteg emberre vagy állatra, aki nagyszámú vírust ürít. A vírus az ürítő székletéből vagy vizeletéből kerülhet közvetlenül az ételbe pl. mosatlan kéz által, de közvetetten is célba juthat, fertőzött vízzel – esetleg szennyvízzel – megöntözött növények vagy fertőzött vízben élő kagylók, halak által, de használati tárgyak segítségével is. Természetesen a vírusok terjedéséhez nem szükséges az élelmiszerbe jutás, emberről emberre közvetlenül is terjedhetnek pl. cseppfertőzés útján vagy szexuális úton.
A vírus szélsőséges körülmények között is túlél, így olyan környezeti behatások, mint a magas vagy a fagypont alatti hőmérséklet csak lassan tesz kárt a fertőző májgyulladás vírusában. A vírus fertőzőképessége nagy és könnyen szóródik, a fertőzés után a lappangási ideje 15–50 nap. A betegség gyakran jellegtelen formában zajlik, sárgaság is ritkán jelentkezik, még egészen kiskorú gyerekeknél is gyakori a tünetmentes lezajlás. A hepatitis A miatti halálozás nagyon ritkán, kivételes esetekben fordul elő. Sok egyéb kórokozóval ellentétben a fertőző májgyulladás összege nem jár tartós vírushordozással. A vírust az általános higiénés szabályok betartása mellett lehet megelőzni.
A hepatitis mellett a legtöbb élelmiszerben is előforduló vírus hasmenéses járványokat okozhat. Leggyakoribb a rota- és calicivírus, melyeknél mindkét esetben az ember a fertőző forrás. A széklettel a külvilágba jutó vírus mosatlan kézzel végzett konyhai munkák, fertőző vízzel vagy szennyvízzel öntözött és nyersen fogyasztott gyümölcsök, zöldségek fogyasztásával terjed tovább. Előfordulhat a terjedés hőkezelés után megfertőzött élelmiszerek fogyasztásával is, például pékáruval, hidegkonyhai készítményekkel, utcai árusoknál kapható ételekkel. A vírus terjedésének megakadályozása miatt is fontos, hogy pékségekben, utcai kifőzdékben, gyorséttermekben fokozottan figyeljünk a személyzet higiénéjére, ha esetleg láthatóan mosatlan kézzel vagy kesztyű, csipesz nélkül szolgálnak ki, egyszerűen ne fogadjuk el az árut. A rotavírus elsősorban csecsemők, kisgyermekek hasmenését okozza, zárt közösségeken – bölcsődében, óvodában az átfertőződések aránya nagyon nagy, akár 80%-os is lehet. A calicivírusok életkortól függetlenül a leggyakoribb nem bakteriális eredetű kiváltói a hasmenésnek, az esetek közel feléért ez a vírus a felelős. A kórokozó nem csak a környezeti hatásoknak, hanem a hagyományos fertőtlenítőszereknek is képes ellenállni, így a megfelelő higiénés szabályok betartása különösen fontos. A megelőzésben a fertőtlenítés mellett szerepet játszik még a szennyvízzel öntözött növények kizárása.